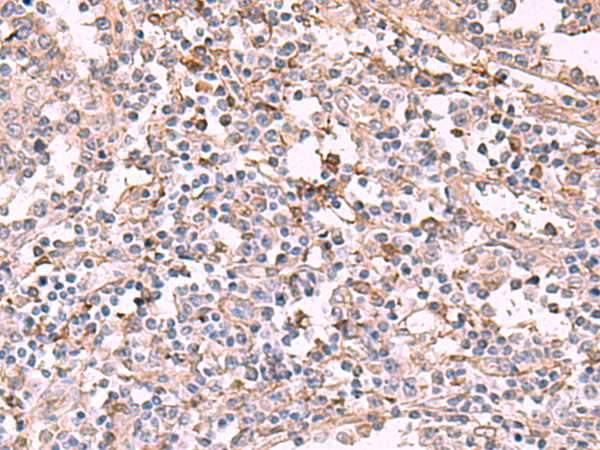

中文名稱: 兔抗ADH1B多克隆抗體
|
Background: |
The protein encoded by this gene is a member of the alcohol dehydrogenase family. Members of this enzyme family metabolize a wide variety of substrates, including ethanol, retinol, other aliphatic alcohols, hydroxysteroids, and lipid peroxidation products. This encoded protein, consisting of several homo- and heterodimers of alpha, beta, and gamma subunits, exhibits high activity for ethanol oxidation and plays a major role in ethanol catabolism. Three genes encoding alpha, beta and gamma subunits are tandemly organized in a genomic segment as a gene cluster. Two transcript variants encoding different isoforms have been found for this gene. |
|
Applications: |
ELISA, WB, IHC |
|
Name of antibody: |
ADH1B |
|
Immunogen: |
Synthetic peptide of human ADH1B |
|
Full name: |
alcohol dehydrogenase 1B (class I), beta polypeptide |
|
Synonyms: |
ADH2; HEL-S-117 |
|
SwissProt: |
P00325 |
|
ELISA Recommended dilution: |
5000-10000 |
|
IHC positive control: |
Human tonsil |
|
IHC Recommend dilution: |
50-300 |
|
WB Predicted band size: |
40 kDa |
|
WB Positive control: |
Raji cell lysate |
|
WB Recommended dilution: |
1000-5000 |

購物車
購物車 幫助
幫助
 021-54845833/15800441009
021-54845833/15800441009
